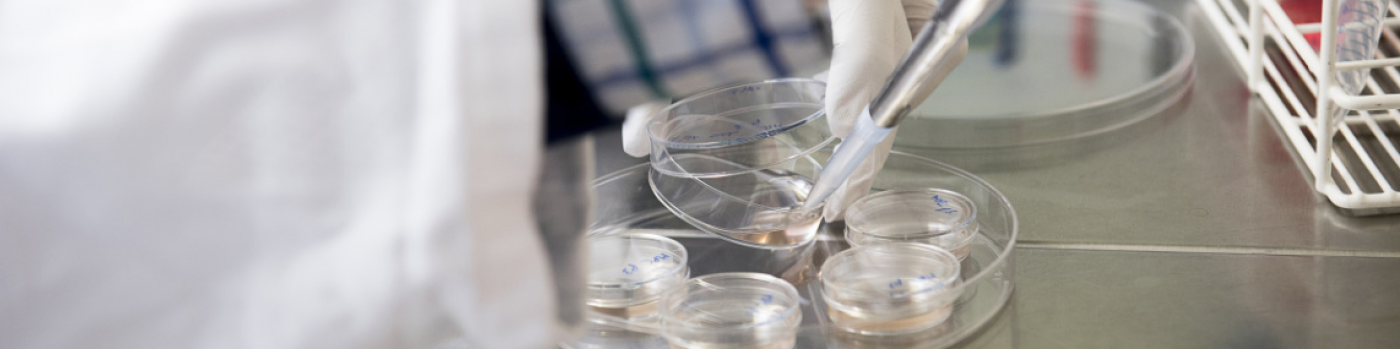
La fin des prothèses ?

Faire repousser les os, régénérer les cartilages… des rêves futuristes qui seront bientôt réalité.
En orthopédie, le 20e siècle a été celui des prothèses. Remplacer les os et le cartilage par des articulations en métal et polymères, c’est bien. Les avancées de la recherche médicale permettent d’espérer mieux : utiliser les briques du vivant, les cellules du corps, pour reconstituer des tissus sains. Le 21e siècle sera-t-il celui des thérapies cellulaires ?
Sur les animaux, ces technologies donnent des résultats parfois spectaculaires. « Avec les humains, c’est autre chose. Les procédés doivent encore être optimisés. Puis il faudra s’assurer de leur innocuité. Mais l’espoir est bien réel. Les premières retombées cliniques sont attendues dans les cinq à dix prochaines années », annonce le Pr Didier Hannouche, médecin-chef du service de chirurgie orthopédique et traumatologie de l’appareil moteur.
Deux méthodes
Les chercheurs explorent essentiellement deux méthodes. Toutes deux exploitent les capacités des cellules dites « souches » à produire différents tissus organiques : os, muscle, cartilage, etc. La première consiste à élaborer les tissus en laboratoire, puis à les greffer sur le patient. La seconde, à injecter directement les cellules souches sur les parties lésées afin de stimuler les fonctions autoréparatrices naturelles de l’organisme. Les enjeux sociaux, mais aussi économiques des résultats de ces recherches sont immenses. L’arthrose, par exemple, qui détruit le cartilage notamment des hanches et des genoux, touche près la moitié de la population mondiale âgée de plus de 65 ans.
Obstacles à lever
« Nous savons déjà greffer du cartilage prélevé sur le patient ou fabriqué in vitro à partir de cellules cartilagineuses. Mais cette technique ne marche que sur des petites lésions de 10 à 15 millimètres de diamètre. Or, celles produites par l’arthrose sont beaucoup plus importantes. A ce stade, la seule solution disponible aujourd’hui c’est la prothèse en métal ou en céramique, qui devra probablement être changée un jour », rappelle le Pr Hannouche. Les thérapies cellulaires, elles, portent l’espoir d’une guérison définitive. Mais de nombreux obstacles doivent toutefois être levés. « Le cartilage élaboré en laboratoire doit encore faire la preuve de ses qualités fonctionnelles et de sa longévité », souligne l’orthopédiste. Du côté des os, les techniques avancent, elles aussi, à grands pas. « Il est possible de réparer des défauts osseux sévères, dans des modèles expérimentaux, en cultivant des cellules sur des matrices résorbables. Mais il est trop tôt pour crier victoire. Ces matrices ne présentent pas encore toutes les propriétés biologiques et mécaniques requises », déplore le Pr Didier Hannouche. Du laboratoire à la clinique, le chemin est encore long. Mais plus personne ne doute qu’on y arrivera, dans un avenir plus ou moins proche.

Les thérapies cellulaires portent l’espoir d’une guérison définitive.
Patchs de cartilage
Aux HUG, une technique pour traiter des lésions localisées du cartilage arrive à bout touchant. Les chercheurs genevois, en collaboration avec la Dre Vannary TiengCaulet et le Pr Karl-Heinz Krause, sont en effet parvenus à recréer en laboratoire des patchs de cartilage utilisable en autogreffe. Ce tissu a été obtenu à partir de chondrocytes, les cellules qui synthétisent la matrice du cartilage. « Ces résultats sont très encourageants », confie Jacques Menetrey, médecin adjoint agrégé, responsable du centre de médecine de l’appareil moteur et du sport. Les essais sur l’être humain devraient débuter prochainement.
« Un second programme de recherche, visant à améliorer la régénération musculaire, pourrait être testé en clinique d’ici trois à cinq ans », indique le Dr Thomas Laumonier, ingénieur de recherche. Son principe est aussi simple à décrire que difficile à réaliser. Des cellules souches adultes – capables de former de nouveaux tissus – sont d’abord isolées à partir d’un muscle du patient. Elles sont ensuite cultivées en laboratoire avant d’être réinjectées dans la lésion musculaire. Cette technique pourrait optimiser la guérison après des blessures sévères.
Dossier Orthopédie
Texte:
- André Koller
Photos:
- Pulsations